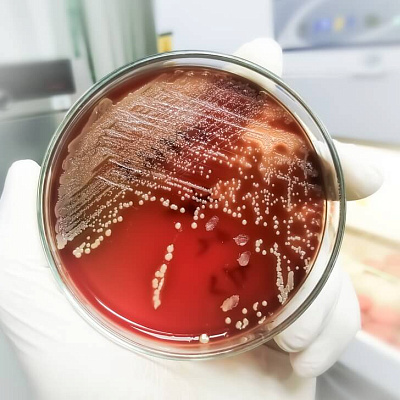

Фурункул у ребенка
Фурункул у ребенка – это острое хирургическое заболевание волосяного фолликула, суть которого заключается в гнойном его расплавлении. Причина образования всегда инфекционная. Основную роль выделяют стафилококку, реже встречаются другие представители условно-патогенной флоры. На фоне снижения защитных сил организма бактерии активируются, развивают воспаление. Кожа в участке поражения отечна, гиперемирована. Вовлечены окружающие фолликул ткани. При малейшем касании ребенок ощущает резкую боль. Если очаг большой, к местным признакам присоединяется общая интоксикация. С такими жалобами пациенту срочно обратиться к детскому хирургу. Врач проведет осмотр, предложит компрессы или сделает операцию. Патология полностью разрешится.

Причины фурункула у ребенка
В 100% случаев гнойник у детей имеет бактериальную природу. Непосредственной причиной частых фурункулов у детей в большинстве случаев становится поражение стафилококком. Реже болезнь вызывают стрептококки. Они больше затрагивают поверхностные слои, не спешат проникнуть в подкожную клетчатку с фолликулами и железами.
Факторы риска
Просто так микроорганизмы усиленно размножаться не могут начать. Слишком активно их контролирует иммунная система. Поддерживает определенное количество, не дает свободно распространяться. Поэтому формирование гнойного очага зачастую обусловлено определенными состояниями:
- снижение защитных сил организма (сопутствующие вирусные инфекции, применение цитостатиков, частое назначение антибиотиков, перенесенные в недавнем прошлом хирургические вмешательства);
- врожденные иммунодефициты;
- нарушение целостности кожи (травмы, расчесы, мацерация, ожоги, хронические дерматологические заболевания);
- неудовлетворительная гигиена кожи;
- сахарный диабет;
- выраженный избыток массы тела;
- частые стрессовые ситуации;
- наличие в организме очагов хронической инфекции (ринит, синусит).
Патогенез
На коже человека в норме живет несколько сотен видов микроорганизмов. Вместе они образуют уникальную условно-патогенную флору. Защищают орган от патогенных частиц, учат противостоять таковым иммунную систему, способствуют увлажнению, питанию, регенерации наружного покрова. То есть, функций много. И все они важны.
До тех пор, пока иммунитет, потовые и сальные железы работают в должном режиме, кожа выполняет свои задачи. Но стоит защите ослабнуть, как бактерии берут верх. Крайне активно размножаются, формируют воспалительный процесс.
В ответ на внедрение патогенов, расширяются кровеносные сосуды, усиливается кровообращение. Клинически это проявляет себя гиперемией.
Жидкая часть крови из сосуда выходит в межклеточное пространство. К местной гиперемии присоединяется отек тканей.
Иммунные клетки организма активно борются с бактериями. И одни, и вторые погибают. Это проявляет себя формированием гнойной пустулы, классического фурункулеза.
Наше исследование показало, что чем меньше возраст пациента, тем хуже течение болезни. Во-первых, развивается она гораздо быстрее, во-вторых, лечение дается с трудом. Причина таких возрастных особенностей кроется в разнице анатомии и физиологии.
У детей с рождения до лет трех встречается болезнь редко. Но протекает тяжело. Иммунная система еще не сформирована, не знает, как отвечать на явные внедрения бактерий. Даже минимальное воспаление приводит к выраженной системной реакции.
Следующий период 3-10 лет. Фурункулы не редкость. Ребенок травмирует кожу, если зудит – неосознанно расчесывает. Появляются все условия для нагноения фолликула. Из положительных моментов, проходит болезнь относительно легко.
У подростков гормональные изменения провоцируют частые рецидивы на лице, шее, спине. Пациенты любят их самостоятельно выдавливать, что повышает риск осложнений, появления грубых рубцов.

Классификация
Разделяют фурункулы у детей по количеству образований:
- одиночные;
- множественные (это состояние называется фурункулез).
По времени возникновения случаются:
- первичные;
- рецидивирующие.
Симптомы фурункула у ребенка
Клинику болезни, беспокоящие пациента симптомы полностью определяет стадия созревания, которой на конкретный момент времени достиг фурункул.
- Первая стадия – инфильтрации. Пока это только гиперемия, отек. При пальпации болезненность, но гноя еще нет. При своевременно начатом лечении операция не понадобится.
- Второй этап развития болезни – гнойного расплавления. Болезнь прогрессирует. В центре красноты появляется очаг флюктуации в виде размягчения. Желтая покрышка означает, что стержень уже сформировался. Боль сохраняется, даже прогрессирует. При больших размерах очага повышается температура тела. Вплоть до высоких цифр, 38-39. Плохо сбивается жаропонижающими. За пару часов снова доходит до исходных значений.
Если пациент в это время обращается к хирургу, врач вскрывает пустулу. Нет, патология прогрессирует. Гной продолжает накапливаться. Ввиду возрастающего давления прорывает капсулу, выходит наружу. Сразу после жалобы разрешаются. Отек, гиперемия постепенно сходит. Практически мгновенно падает температура тела. Состояние ребенка явно улучшается. - Последний этап – заживления. После очищения полости от некротизированных тканей, рана заживает вторичным натяжением. Оставляет после себя разного размера рубец.
Осложнения
Фурункул у детей – заболевание, которое требует буквально немедленной терапии. Если пациент не обращается к врачу, не проходит лечение, гнойно-септический процесс быстро распространяется по всему организму. Последствий не миновать. Среди таких:
- У детей инфекция быстро затрагивает окружающие и глублежащие ткани, формирует флегмону – опасное состояние, когда гной растекается по всей анатомической области. Одним маленьким разрезом в таком случае уже не обойтись. Хирург будет вынужден вскрывать очаг вдоль, поперек, лампасно. Что, конечно, скажется на эстетике.
- Помимо мягких тканей, бактерии могут затронуть кость. Спровоцировать остеомиелит со всеми вытекающими из него последствиями.
- Воспаляются на фоне поражения лимфатические узлы. Приходится попутно лечить лимфангит, лимфаденит.
- И самым опасным последствием становится сепсис. Патогенные микроорганизмы проникают в системный кровоток. Пациенту требуется экстренная помощь уже в отделении реанимации.

У детей приблизительно 60% всех гнойников появляются на лице: губы, нос, в области уха. Часто встречаются образования на шее. Опасность данной локализации – близость к органу зрения, головному мозгу. При неправильном лечении или его отсутствии гной быстро распространяется по венозным синусам, лимфатической сети. Вовлекает в себя критично важные для жизни органы и ткани. В отдаленном периоде пациент страдает от неврологического дефицита, когнитивного снижения, потери функции органов чувств.
Диагностика фурункула у детей
Диагностика фурункула у ребенка относится к разряду срочных. То есть посетить врача или вызвать детского хирурга на дом нужно как можно раньше. В этот же день после обнаружения проблемы, максимум в следующий.
Начнется визит с беседы. Родители или сам пациент расскажет о жалобах. Доктору важно знать, когда появились первые местные проявления, повышалась ли температура тела. В какой момент очаг стал не твердым, а мягким, болит ли в месте прилежащих лимфоузлов.
После хирург приступит к осмотру. Обнаружение очага воспаления с отеком и флюктуацией, по сути, уже основа диагноза и выбора способа лечения гнойника.
Остальные обследования могут потребоваться при подозрении на осложнения. Врач предложит пройти:
- лабораторные анализы (для уточнения, насколько выражена системная интоксикация организма инфекцией);
- микробиологическое исследование гноя на выявление конкретного микроорганизма и чувствительность к антибиотикам (для назначения этиотропного лечения);
- УЗИ мягких тканей (оценка величины очага, распространения по мышцам, подкожной клетчатке);
- рентгенография (при подозрении на вовлечение кости);
- консультация узких специалистов при подозрении на вовлечение рядом расположенных органов (глаз, нос, пазухи).
Детальное обследование дает специалисту возможность точно выставить диагноз. Определить единственно верную тактику лечения.
Лечение фурункула у ребенка
На первых стадиях развития врач может порекомендовать консервативную терапию, отправить пациента домой. Но с условием обязательного контроля через несколько дней. Созревшие гнойники, со стержнем внутри, компрессами не вылечить, нужно вскрывать. В зависимости от возраста, общего состояния человека, выраженности процесса и еще многих факторов, операция проводится амбулаторно или в условиях стационара.
Консервативное лечение применяется при инфильтративной форме, когда есть только отек и воспаление. Врач назначает нестероидные противовоспалительные средства местно и внутрь, полуспиртовые компрессы. Есть шанс, что очаг разрешится. Пациентам с частыми рецидивами показаны антибиотики.
При формировании стержня лечение строго хирургическое. Этапы операции:
- Анестезия. У детей постарше применяются местные анестетики. Для выключения болевого синдрома достаточно местно обколоть рану. Малыши, напротив, полежать спокойно не смогут. Нужен общий наркоз.
- Разрез. Выполняется он в месте наибольшей флюктуации, в центре желтой покрышки.
- Очищение раны. Хирург удаляет гной, некротизированные ткани. Промывает рану растворами антисептиков.
- Дренирование. В завершении операции специалист устанавливает в рану дренаж для дальнейшего очищения полости.
- Наложение стерильных повязок.
После окончания операции врач назначает дополнительное консервативное лечение: антибиотики, иммуномодуляторы, противовоспалительные, если есть на то необходимость. Сообщает даты следующих перевязок. Как правило, за неделю рана полностью заживает. Лечение заканчивается.
Прогноз и профилактика
Прогноз благоприятный. Затягивать с обращением к врачу даже не получится. Слишком сильно ребенку болит, родители плохо справляются с температурой, системной реакцией. Сразу на первой консультации врач проводит основное лечение. За пару последующих посещений пациент выздоравливает.
В дальнейшем нужно только соблюдать правила профилактики. Чтобы болезнь заново не повторилась. Специалисты рекомендуют:
- стараться лишний раз не травмировать кожу;
- не расчесывать;
- поддерживать гигиену кожи;
- выбирать одежду из натуральных тканей;
- наблюдаться у врача по поводу хронических заболеваний;
- укреплять иммунитет (закаливание, режим дня, прогулки);
- принимать витамины;
- сбалансировать питание;
- контролировать массу тела;
- исключить стрессы.
Четкое следование рекомендациям врача явно уменьшит риск повторного образования фурункула у ребенка.
Источники
- Г.В. Слизовский, И.И. Кужеливский. «Детские хирургические болезни», 2015.
- Российская ассоциация детских хирургов. Национальное руководство. Детская хирургия.
- Российское общество дерматовенерологов и косметологов. Клинические рекомендации. Пиодермии. 2025.

Ответы на вопросы
Можно ли вскрыть или выдавить фурункул самостоятельно?
Очень опасная ситуация, когда родитель или подросток на второй стадии видит пустулу, самостоятельно выдавливает гнойный стержень. Удача, если весь патологический субстрат выходит наружу. Состояние улучшается, рана заживает. Но есть очень высокий риск, что оставшаяся часть проникнет внутрь, попадет в системный кровоток. Последствия такого выдавливания резко становятся неблагоприятными.
Можно греть фурункулы?
Нет, греть фурункулы у детей категорически нельзя. Прогревание участка воспаления на любой из стадий чревато распространением инфекции. Бактерии в благоприятных для себя условиях быстро размножаются. Вовлекают в себя все больше анатомических структур. Болезнь не разрешается, а только прогрессирует. Приводит к осложнениям.
Фурункул у ребенка может пройти без лечения?
Теоретически да. Есть шанс, что очаг инфекции самостоятельно прорвется, весь гной выйдет и рана заживет. Но на практике надеяться на это не стоит. Полностью гнойник без вмешательства хирурга очищается редко. Получается, что риск осложнений гораздо выше вероятности самостоятельного разрешения, и лучше все-таки обратиться к врачу.
Есть ли народные методы лечения гнойника?
Нет, таких не существует. Ни один способ народной медицины не доказал свою эффективность. Зато каждый из них то и дело демонстрирует нежелательные реакции: ожоги, прогрессирование гнойного процесса, аллергический ответ организма и многие другие. Поэтому заниматься самолечением однозначно не стоит. Важно как можно раньше обратиться к специалисту. Пройти клинически верное, доказавшее свою эффективность и безопасность, лечение.
Заболевания по направлению Детский хирург
Лицензии

Мы осуществляем деятельность на основании медицинских лицензий в соответствии с рекомендациями Минздрава